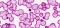

VALENCIA. El Plan de Ajuste presentado por el actual Gobierno de Gandia en julio y que contemplaba drásticas medidas de austeridad, ha sido aprobado por el Ministerio de Hacienda. Una noticia agridulce pues, aunque permitirá a Gandia reducir la deuda de 230 millones de euros, los ciudadanos “tendrán que hacer también un esfuerzo”.
Así lo ha expresado esta mañana la alcaldesa socialista Diana Morant, quién se ha mostrado esperanzada ante este anuncio que garantiza que “Gandia tenga viabilidad económica y social” a la vez que ha lamentado que sean los ciudadanos quienes tengan que sufrir estas políticas tan austeras. Por ello, el Gobierno ha anunciado que se tomarán medidas para “depurar todas las responsabilidades para que los anteriores gestores y responsables de este rescate paguen por las decisiones que tomaron con el dinero de todos los gandienses”.
Igualmente, el Gobierno ha anunciado que mantendrá reuniones con asociaciones, entidades bancarias y proveedores para explicar las medidas que se van a adoptar para hacer frente a sus deudas y compromisos.
El Plan de Ajuste para la Refinanciación de la Deuda de Gandia fue aprobado en julio con los votos del PSOE, Més Gandia y Ciudadanos Gandia y tiene como objetivo reducir la deuda, tanto bancaria como a proveedores, que asciende a los 320 millones de euros. Al respecto, la primera edil ha recordado la negativa del Partido Popular en aprobar este plan financiero y les ha pedido “reflexión” y “apoyo”.
El plan contempla recortes en el gasto del ayuntamiento, un 5% en la reducción de personal municipal; la redistribución de efectivos; la jubilación forzosa de personal del consistorio a los 65 años; la reducción del personal de confianza, así como la reducción drástica de subvenciones y convenios. En cuanto al capítulo de ingresos, el consistorio acometerá subidas impositivas de un 24% en el IBI, y de un 20% en el Impuesto sobre Vehículos de Tracción Mecánica.
Mensaje de esperanza
Para la vicealcaldesa de Gandia, Lorena Milvaques, con la aprobación de este Plan de Ajuste se abre “la esperanza para el ayuntamiento y para la ciudad”. En su opinión, a partir de ahora el Gobierno podrá acogerse a mecanismos como la refinanciación de la duda a bancos o a futuros planes que ayudaran a las pequeñas y medianas empresas a salir también de la crisis.